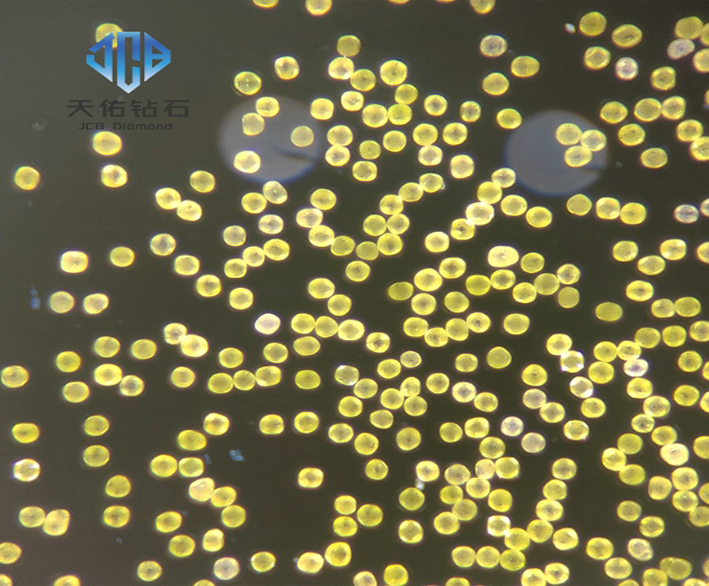

Tianyou 단결정 초경질 재료에는 고온 고압법 단결정 다이아몬드, CVD법 단결정 다이아몬드 및 입방정 질화붕소 등이 포함됩니다. 고온 고압법 단결정 다이아몬드는 조립된 납석 합성 블록을 6개의 공동에 배치하는 것입니다. 양면 상단 프레스. 고온, 고압 후 단결정 성장을 연장하고 합성 블록을 꺼내 정제하여 단결정을 선별하고 분류하는 고온 고압법을 이용한 단결정 다이아몬드의 특징은 대량 생산의 발달과 함께 높은 경도와 규칙적인 결정 격자 배열입니다. 대형 6면 탑 프레스 기술, 고온 고압 방식으로 생산되는 단결정 다이아몬드의 크기도 점점 커지고 있습니다.